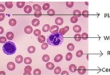
Total Count of RBC, WBC and Platelet

Oral Glucose Tolerance Test Introduction Diabetes is one of the most rapidly growing health concerns …
Read More »Best Pathology course in Mirpur-10.
Best Pathology course 01797522136 The healthcare sector in Bangladesh is expanding rapidly, creating a growing demand for skilled medical professionals, particularly in diagnostic and laboratory services. Among these, pathology plays a crucial role in disease diagnosis, prevention, and treatment planning. As a result, pursuing a Best Pathology course .Pathology has …
Read More »
Pathology Training Institute in Bangladesh Best Pathology Training Institute in Bangladesh